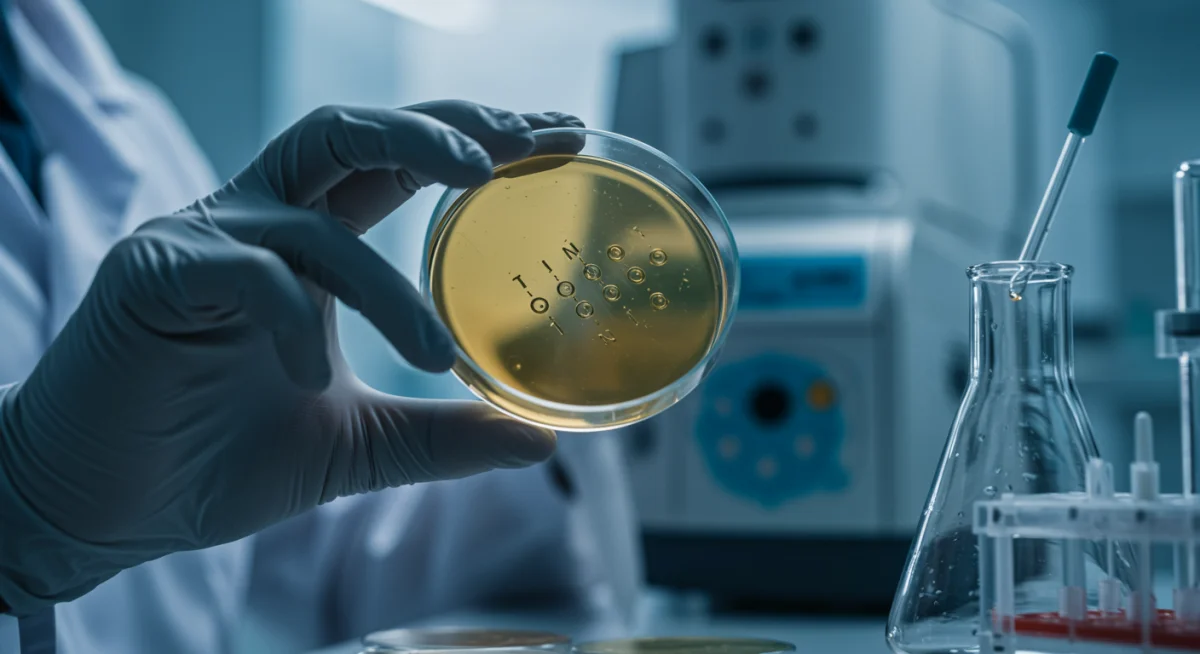
Científico examinando un nuevo ingrediente activo en un laboratorio moderno.

¿Piel perfecta en 2025? Ingredientes activos que revolucionarán tu rutina
Anúncios
¿Se puede alcanzar la piel perfecta en 2025? La respuesta es un rotundo sí, y la clave reside en la constante innovación de la ciencia cosmética. Este año no solo trae nuevas tendencias, sino también tres ingredientes activos revolucionarios que prometen transformar por completo tu rutina de belleza y ofrecer resultados visibles en menos tiempo de lo esperado. Prepárate para descubrir cómo estos componentes de vanguardia están redefiniendo el futuro del cuidado de la piel.
Anúncios
La promesa de la piel perfecta en 2025: una realidad al alcance de tu mano
La búsqueda de una piel impecable ha sido una constante a lo largo de la historia, y en 2025, esta aspiración se vuelve más tangible que nunca. Gracias a los avances científicos y a una comprensión más profunda de la biología cutánea, la industria cosmética ha desarrollado ingredientes activos capaces de abordar múltiples preocupaciones de la piel con una eficacia sin precedentes. Ya no se trata solo de cubrir imperfecciones, sino de tratar desde la raíz los problemas para lograr una salud dérmica óptima.
Este año marca un punto de inflexión, donde la personalización y la ciencia de precisión se unen para ofrecer soluciones adaptadas a cada tipo de piel. Los consumidores españoles están cada vez más informados y buscan productos que no solo prometan, sino que cumplan. La transparencia en la formulación y la sostenibilidad en la producción son factores que también ganan terreno, complementando la eficacia de estos nuevos activos.
El enfoque integral del cuidado de la piel
Lograr una piel perfecta no se limita a un solo producto o ingrediente. Es el resultado de un enfoque integral que combina una rutina de cuidado adecuada, un estilo de vida saludable y, por supuesto, la inclusión de activos innovadores. Estos nuevos ingredientes actúan en sinergia con los componentes ya conocidos, potenciando sus efectos y ofreciendo una solución más completa.
Anúncios
- Hidratación profunda: Clave para una barrera cutánea fuerte y elástica.
- Protección antioxidante: Escudo contra el daño de los radicales libres y el envejecimiento prematuro.
- Renovación celular: Fomenta la regeneración de la piel para una textura suave y uniforme.
- Estimulación de colágeno: Mantiene la firmeza y reduce la aparición de arrugas.
La meta para la piel perfecta en 2025 es una piel no solo libre de imperfecciones, sino también resiliente, luminosa y con un aspecto juvenil duradero. Estos nuevos ingredientes activos son los pilares de esta nueva era en el cuidado de la piel, permitiendo a cada individuo adaptar su rutina para satisfacer sus necesidades específicas y alcanzar sus objetivos de belleza.
Ingrediente activo 1: El bio-péptido de fermentación avanzada
El primer protagonista en nuestra lista de ingredientes revolucionarios es el bio-péptido de fermentación avanzada. Este innovador compuesto no es un péptido común; se obtiene a través de un proceso biotecnológico de fermentación que amplifica su potencia y biodisponibilidad. Su estructura molecular única le permite penetrar las capas más profundas de la piel, donde ejerce su acción reparadora y rejuvenecedora con una eficacia notable.
Los estudios preliminares han demostrado que este bio-péptido tiene un impacto significativo en la mejora de la elasticidad y la firmeza de la piel. Actúa estimulando la producción de colágeno y elastina, dos proteínas esenciales para mantener la estructura y la juventud de la dermis. A medida que envejecemos, la producción de estas proteínas disminuye, lo que lleva a la formación de arrugas y a la pérdida de tonicidad. El bio-péptido de fermentación avanzada contrarresta este proceso, revitalizando la piel desde el interior.
Mecanismo de acción y beneficios clave
El mecanismo de acción de este bio-péptido es multifacético. No solo estimula la síntesis de proteínas estructurales, sino que también posee propiedades antioxidantes que protegen las células del daño oxidativo. Esto se traduce en una piel más resistente frente a los agresores ambientales, como la contaminación y la radiación UV, que son factores clave en el envejecimiento prematuro.
- Reducción de arrugas: Rellena las líneas de expresión y arrugas profundas.
- Mejora de la elasticidad: Aporta mayor flexibilidad y resistencia a la piel.
- Firmeza visible: Combate la flacidez y redefine el contorno facial.
- Protección antioxidante: Neutraliza los radicales libres, previniendo el daño celular.
La inclusión de este bio-péptido en tu rutina de belleza para la piel perfecta en 2025 significa apostar por una tecnología de vanguardia que ofrece resultados duraderos y visibles. Es ideal para quienes buscan una solución antienvejecimiento potente que mejore la calidad general de la piel, dejándola más suave, tersa y con un aspecto rejuvenecido.
Ingrediente activo 2: El complejo de ceramidas biomiméticas
El segundo ingrediente que está marcando la diferencia en la búsqueda de la piel perfecta en 2025 es el complejo de ceramidas biomiméticas. Las ceramidas son lípidos esenciales que constituyen una parte crucial de la barrera cutánea, actuando como el “cemento” que une las células de la piel. Una barrera cutánea fuerte es fundamental para retener la humedad y proteger la piel de irritantes y alérgenos externos.
Sin embargo, con la edad y debido a factores ambientales, los niveles de ceramidas naturales en la piel disminuyen, lo que puede llevar a sequedad, sensibilidad, irritación y una mayor propensión a condiciones como el eccema. Los complejos de ceramidas biomiméticas están diseñados para imitar la estructura y función de las ceramidas naturales de la piel, reponiendo eficazmente estos lípidos y restaurando la integridad de la barrera cutánea.
Restauración de la barrera y beneficios para pieles sensibles
La restauración de la barrera cutánea es el principal beneficio de las ceramidas biomiméticas. Al fortalecer esta barrera, la piel se vuelve más resistente a la pérdida de agua transepidérmica, lo que resulta en una hidratación más profunda y duradera. Esto es especialmente beneficioso para personas con piel seca, deshidratada o sensible, que a menudo experimentan una barrera cutánea comprometida.
- Hidratación intensa: Previene la pérdida de humedad y mantiene la piel hidratada.
- Fortalecimiento de la barrera: Mejora la función protectora natural de la piel.
- Reducción de la sensibilidad: Calma la piel irritada y reduce el enrojecimiento.
- Protección contra irritantes: Actúa como un escudo contra agentes externos dañinos.
La incorporación de un complejo de ceramidas biomiméticas en tu rutina es un paso esencial hacia la piel perfecta en 2025, especialmente si buscas mejorar la salud general de tu piel y protegerla de los desafíos diarios. Este ingrediente no solo hidrata, sino que también repara y refuerza, creando una base sólida para una piel radiante y equilibrada.
Ingrediente activo 3: El extracto de microalgas adaptógenas
El tercer ingrediente que está revolucionando el mundo de la belleza para la piel perfecta en 2025 es el extracto de microalgas adaptógenas. Las adaptógenas son sustancias naturales que ayudan al organismo a adaptarse al estrés, y en el contexto de la piel, esto se traduce en una mayor capacidad para resistir los efectos negativos del estrés ambiental y oxidativo. Las microalgas, en particular, son una fuente rica en compuestos bioactivos con propiedades únicas.
Este extracto se obtiene de microalgas que prosperan en condiciones extremas, lo que les confiere una resistencia y capacidad de adaptación excepcionales. Cuando se aplican sobre la piel, estas propiedades se transfieren, ayudando a las células cutáneas a defenderse y recuperarse del daño. El estrés oxidativo, causado por factores como la exposición solar, la contaminación y el estilo de vida, es uno de los principales contribuyentes al envejecimiento prematuro y a la aparición de imperfecciones.
Adaptación y resistencia cutánea al estrés
El extracto de microalgas adaptógenas actúa como un potente escudo protector. Su riqueza en antioxidantes, vitaminas y minerales ayuda a neutralizar los radicales libres y a reducir la inflamación. Además, mejora la capacidad de la piel para autorrepararse y regenerarse, lo que resulta en una tez más uniforme, luminosa y con un aspecto más joven.
- Protección anti-estrés: Ayuda a la piel a resistir el daño ambiental.
- Acción antioxidante: Combate los radicales libres y previene el envejecimiento.
- Mejora de la luminosidad: Aporta un brillo saludable y uniforme a la piel.
- Regeneración celular: Promueve la renovación de las células cutáneas.
Incluir el extracto de microalgas adaptógenas en tu rutina de cuidado de la piel en 2025 es una estrategia inteligente para proteger tu piel del día a día y mantenerla en su mejor estado. Este ingrediente es ideal para aquellos que viven en entornos urbanos o están expuestos a altos niveles de estrés, ya que ofrece una defensa activa y visible contra los signos del envejecimiento y la fatiga cutánea.
Integrando los nuevos activos en tu rutina de belleza
La clave para lograr la piel perfecta en 2025 con estos nuevos ingredientes activos no solo radica en su eficacia individual, sino en cómo se integran de manera inteligente en tu rutina diaria. No se trata de sobrecargar la piel con demasiados productos, sino de seleccionar aquellos que contengan los activos más adecuados para tus necesidades específicas y aplicarlos en el orden correcto para maximizar su absorción y beneficios.
Una rutina bien estructurada comienza con una limpieza suave pero efectiva, seguida de la aplicación de sueros y tratamientos concentrados que contengan estos ingredientes innovadores. Finaliza con una crema hidratante que selle los activos y una protección solar adecuada durante el día. La constancia es fundamental; los resultados visibles tardan tiempo en manifestarse, pero con un uso regular, la transformación de tu piel será sorprendente.
Orden de aplicación y sinergias
Para optimizar la eficacia, es importante considerar el orden de aplicación. Generalmente, los productos más ligeros (sueros) se aplican antes que los más densos (cremas). Además, algunos ingredientes activos pueden trabajar en sinergia, potenciando sus efectos mutuamente. Por ejemplo, la combinación del bio-péptido de fermentación avanzada con el complejo de ceramidas biomiméticas puede ofrecer una mejora significativa en la firmeza y la hidratación.
- Paso 1: Limpieza: Prepara la piel para una mejor absorción de los activos.
- Paso 2: Suero con bio-péptido: Actúa sobre arrugas y flacidez.
- Paso 3: Hidratante con ceramidas: Fortalece la barrera y retiene la humedad.
- Paso 4: Tratamiento específico con microalgas: Protege y revitaliza la piel del estrés.
- Paso 5: Protección solar (día): Imprescindible para prevenir el daño solar.
Experimentar con diferentes combinaciones y observar cómo reacciona tu piel es crucial. Consulta a un dermatólogo o a un profesional de la estética si tienes dudas sobre qué productos son los más adecuados para tu tipo de piel y preocupaciones específicas. La personalización es la piedra angular de la piel perfecta en 2025.
Casos de éxito y testimonios para la piel perfecta en 2025
La eficacia de estos nuevos ingredientes activos no se limita a la teoría científica; ya existen numerosos casos de éxito y testimonios que avalan su poder transformador en la piel. Personas de diversas edades y con distintas preocupaciones cutáneas han experimentado mejoras significativas al incorporar estos compuestos en sus rutinas de belleza. Desde la reducción visible de arrugas hasta una hidratación profunda y una mayor luminosidad, los resultados hablan por sí solos.
En España, cada vez más entusiastas de la belleza comparten sus experiencias positivas, destacando cómo su piel ha recuperado una vitalidad que creían perdida. Estos relatos no solo inspiran, sino que también ofrecen una perspectiva real sobre lo que se puede esperar al adoptar las innovaciones más recientes en el cuidado de la piel. La credibilidad se construye a través de la experiencia personal y la validación por parte de la comunidad.

Experiencias transformadoras de usuarios
Un ejemplo común es el de personas que luchaban contra la sequedad persistente y la sensibilidad. Al introducir productos con complejos de ceramidas biomiméticas, han reportado una disminución drástica en la irritación y una piel mucho más confortable y suave. Del mismo modo, aquellos preocupados por los signos del envejecimiento han notado una mejoría en la firmeza y una reducción en la profundidad de las líneas de expresión gracias al bio-péptido de fermentación avanzada.
- Testimonio 1: Cliente con piel sensible: “Mis rojeces han desaparecido y mi piel se siente mucho más fuerte.”
- Testimonio 2: Cliente con arrugas: “Las líneas de mi frente se han suavizado notablemente en solo unas semanas.”
- Testimonio 3: Cliente con piel apagada: “Mi piel está más luminosa que nunca, incluso sin maquillaje.”
- Testimonio 4: Cliente con piel estresada: “El extracto de microalgas ha sido un salvavidas para mi piel en la ciudad.”
Estos testimonios no son solo anécdotas; reflejan una tendencia creciente hacia la adopción de ingredientes respaldados por la ciencia para lograr una piel sana y radiante. La transparencia y la compartición de experiencias reales son fundamentales para construir la confianza en estos nuevos avances y guiar a otros en su propio camino hacia la piel perfecta en 2025.
Consejos adicionales para potenciar la eficacia de tus activos
Más allá de la elección de los ingredientes activos, existen una serie de prácticas y hábitos que pueden potenciar significativamente su eficacia y acelerar tu camino hacia la piel perfecta en 2025. El cuidado de la piel es un reflejo de tu bienestar general, y abordar aspectos como la nutrición, la hidratación interna y la protección ambiental es tan importante como los productos que aplicas tópicamente.
Considera tu rutina de belleza como una parte de un enfoque holístico para la salud de tu piel. Pequeños cambios en tu estilo de vida pueden marcar una gran diferencia en la forma en que tu piel responde a los tratamientos y en su capacidad para regenerarse y mantenerse saludable. La constancia y la disciplina son tus mejores aliados en este viaje.
Hábitos saludables para una piel radiante
La alimentación juega un papel crucial. Una dieta rica en antioxidantes, vitaminas y ácidos grasos omega-3 puede nutrir la piel desde el interior, complementando la acción de los ingredientes activos. Beber suficiente agua es igualmente vital para mantener la piel hidratada y favorecer la eliminación de toxinas. Además, la calidad del sueño es un factor subestimado; durante el descanso nocturno, la piel se repara y se regenera.
- Dieta equilibrada: Incorpora frutas, verduras y grasas saludables.
- Hidratación interna: Bebe al menos 2 litros de agua al día.
- Sueño reparador: Duerme entre 7 y 9 horas para una regeneración óptima.
- Protección solar diaria: Usa protector solar incluso en días nublados.
- Gestión del estrés: Practica técnicas de relajación para reducir el impacto del estrés en la piel.
Al combinar estos consejos con la aplicación regular de productos que contienen el bio-péptido de fermentación avanzada, el complejo de ceramidas biomiméticas y el extracto de microalgas adaptógenas, estarás creando el ambiente ideal para que tu piel prospere. La piel perfecta en 2025 no es solo un sueño, es el resultado de una estrategia de cuidado inteligente y consistente.
Tendencias futuras y la evolución hacia la piel perfecta en 2025
La industria de la belleza es un campo en constante evolución, y la búsqueda de la piel perfecta en 2025 no se detiene aquí. Más allá de los ingredientes activos que hemos explorado, las tendencias futuras apuntan hacia una personalización aún mayor, impulsada por la inteligencia artificial y la genómica. Imaginamos un futuro donde los productos se formulen basándose en el análisis detallado del ADN de cada individuo, ofreciendo soluciones ultra-personalizadas.
La sostenibilidad y la ética también continuarán siendo pilares fundamentales. Los consumidores demandarán no solo eficacia, sino también productos respetuosos con el medio ambiente y producidos de manera justa. La biotecnología seguirá siendo una fuente inagotable de nuevos descubrimientos, con el desarrollo de ingredientes aún más potentes y específicos, capaces de abordar desafíos cutáneos que hoy parecen insuperables.
Innovación continua y personalización extrema
La investigación en el microbioma cutáneo, por ejemplo, está abriendo nuevas vías para comprender cómo las bacterias que viven en nuestra piel influyen en su salud y apariencia. Los productos que equilibren este ecosistema microscópico serán cada vez más relevantes. Asimismo, la integración de dispositivos inteligentes en las rutinas de belleza permitirá un monitoreo en tiempo real de la piel y la adaptación dinámica de los tratamientos.
- Análisis genómico: Productos adaptados al ADN individual.
- Microbioma cutáneo: Fórmulas que equilibran la flora bacteriana de la piel.
- Dispositivos inteligentes: Monitoreo y ajuste en tiempo real de la rutina.
- Sostenibilidad: Ingredientes y empaques eco-responsables.
- Biotecnología avanzada: Desarrollo de nuevas moléculas con mayor eficacia.
Estos avances prometen llevar la piel perfecta en 2025 a un nivel completamente nuevo, haciendo que el cuidado de la piel sea más preciso, efectivo y adaptado a las necesidades cambiantes de cada persona. Mantenerse informado sobre estas tendencias emergentes es clave para estar a la vanguardia de la belleza y asegurar que tu piel reciba siempre lo mejor que la ciencia tiene para ofrecer.
| Ingrediente Activo | Beneficio Principal |
|---|---|
| Bio-péptido de fermentación avanzada | Estimula colágeno, reduce arrugas y mejora firmeza. |
| Ceramidas biomiméticas | Restaura barrera cutánea, hidrata y calma piel sensible. |
| Extracto de microalgas adaptógenas | Protege del estrés ambiental, antioxidante y revitalizante. |
| Rutina personalizada | Clave para maximizar los beneficios y resultados duraderos. |
Preguntas frecuentes sobre la piel perfecta en 2025
Estos ingredientes son revolucionarios por su origen biotecnológico avanzado, que les confiere una mayor potencia y especificidad. Actúan a nivel celular para abordar problemas específicos, ofreciendo resultados más rápidos y duraderos que los activos tradicionales.
Sí, generalmente pueden usarse juntos, ya que cada uno aborda diferentes aspectos de la salud de la piel. Sin embargo, es crucial introducir los productos gradualmente y observar cómo reacciona tu piel, especialmente si tienes sensibilidad. Consulta a un experto para una rutina personalizada.
Los resultados pueden variar según el individuo y la constancia de uso. Generalmente, se pueden observar mejoras significativas en la textura, hidratación y luminosidad de la piel en unas pocas semanas, mientras que los efectos antienvejecimiento más profundos pueden requerir de 2 a 3 meses de uso regular.
Muchos de estos ingredientes han sido formulados para ser bien tolerados. Las ceramidas biomiméticas, en particular, son excelentes para pieles sensibles. No obstante, siempre se recomienda realizar una prueba de parche y consultar a un dermatólogo si tienes preocupaciones específicas o condiciones cutáneas preexistentes.
Estos ingredientes innovadores están comenzando a aparecer en formulaciones de marcas de cosmética de alta gama y en dermocosmética. Puedes encontrarlos en farmacias, perfumerías especializadas y tiendas online de belleza. Investiga las etiquetas de los productos y busca formulaciones transparentes que destaquen estos activos.
Conclusión: el futuro radiante de tu piel
La búsqueda de la piel perfecta en 2025 se ha transformado en una emocionante aventura científica, y los tres ingredientes activos que hemos explorado —el bio-péptido de fermentación avanzada, el complejo de ceramidas biomiméticas y el extracto de microalgas adaptógenas— son, sin duda, los pioneros de esta nueva era. Estos compuestos no solo prometen, sino que entregan resultados tangibles, ofreciendo soluciones avanzadas para una piel más joven, saludable y resiliente. Al integrar estos innovadores activos en tu rutina de belleza, combinándolos con hábitos de vida saludables y una protección constante, estarás invirtiendo en el futuro radiante de tu piel. La personalización y la ciencia de vanguardia son las claves para desbloquear todo el potencial de tu tez, permitiéndote disfrutar de una belleza duradera y auténtica. Es el momento de abrazar la innovación y transformar tu cuidado facial para una piel perfecta en 2025 y más allá.





